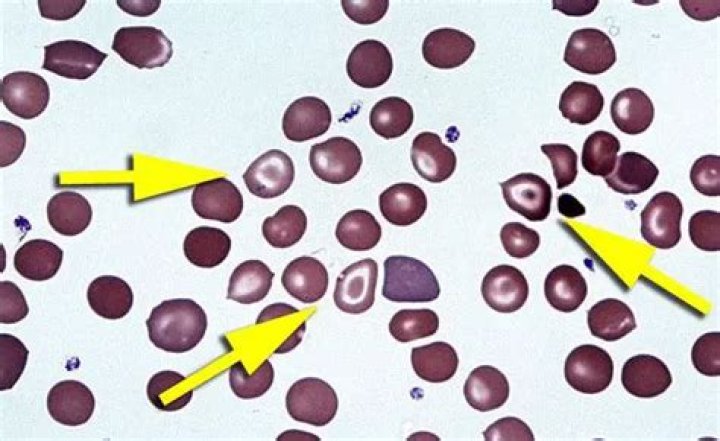

The RANK() function is a window function that assigns a rank to each row within a partition of a result set. The rows within a partition that have the same values will receive the same rank. … RANK() OVER ( [PARTITION BY partition_expression, … ] ORDER BY sort_expression [ASC | DESC], … )
What does rank () do in SQL?
The RANK() function is a window function could be used in SQL Server to calculate a rank for each row within a partition of a result set. The same rank is assigned to the rows in a partition which have the same values.
What is count over in SQL?
SQL Select Count of ResultSet Rows using COUNT(*) OVER PARTITION BY. … You can see the number of rows within the returned sql result set is displayed in an additional sql column TotalRows. Actually, the SQL Count() Over Partition By syntax is a similar tsql usage of the ROW_NUMBER Over Partition By syntax.
What is over in SQL Server?
The OVER clause was added to SQL Server “way back” in SQL Server 2005, and it was expanded upon in SQL Server 2012. … The OVER clause is used to determine which rows from the query are applied to the function, what order they are evaluated in by that function, and when the function’s calculations should restart.What is difference between Row_number and rank?
The rank of a row is one plus the number of ranks that come before the row in question. Row_number is the distinct rank of rows, without any gap in the ranking.
What is rank in database?
Database Ranking is a method of filtering at the query level that allows a smaller selection of records based on ranking on a particular field. Database ranking uses functions built in at the database level to limit selections to only to top or bottom number of records or the top or bottom percentage of records.
What is rank Dense_rank and Row_number?
The RANK, DENSE_RANK and ROW_NUMBER functions are used to get the increasing integer value, based on the ordering of rows by imposing ORDER BY clause in SELECT statement. When we use RANK, DENSE_RANK or ROW_NUMBER functions, the ORDER BY clause is required and PARTITION BY clause is optional.
What is the difference between rank and Dense_rank in SQL with example?
RANK() will assign the same number for the row which contains the same value and skips the next number. DENSE_RANK () will assign the same number for the row which contains the same value without skipping the next number. … The 5th salary column has the same salary as row four so it’s a tie.How do you rank data in SQL?
- We use PARTITION BY Studentname clause to perform calculations on each student group.
- Each subset should get rank as per their Marks in descending order.
- The result set uses Order By clause to sort results on Studentname and their rank.
The Row_Number function is used to provide consecutive numbering of the rows in the result by the order selected in the OVER clause for each partition specified in the OVER clause. It will assign the value 1 for the first row and increase the number of the subsequent rows.
Article first time published onWhat is over in MySQL?
The OVER clause in MySQL is used with the PARTITION BY clause to break the data into partitions. The specified function is going to operate for each partition. …
What does count over do?
COUNT(*) OVER () is a windowed aggregate. The absence of any PARTITION BY or ORDER BY clause means that the window it operates on is the whole result set.
What does count over mean?
transitive verb. : to count more of (people or things) than is accurate overcounted the votes overcounted the number of students enrolled.
How do I count counts greater than 1 in SQL?
- SELECT user_id ,COUNT(*) count.
- FROM PAYMENT.
- GROUP BY account,user_id ,date.
- Having COUNT(*) > 1.
Is RANK faster than row number?
row_number() is slower than equivalent rank() #5298.
What is the difference between ROW_NUMBER and Dense_rank in SQL?
Difference between RANK, DENSE_RANK and ROW_NUMBER Functions The only difference between RANK, DENSE_RANK and ROW_NUMBER function is when there are duplicate values in the column being used in ORDER BY Clause.
Why would I use Dense_rank instead of rank?
RANK gives you the ranking within your ordered partition. Ties are assigned the same rank, with the next ranking(s) skipped. So, if you have 3 items at rank 2, the next rank listed would be ranked 5. DENSE_RANK again gives you the ranking within your ordered partition, but the ranks are consecutive.
What is the difference between rank and dense rank?
RANK and DENSE_RANK will assign the grades the same rank depending on how they fall compared to the other values. However, RANK will then skip the next available ranking value whereas DENSE_RANK would still use the next chronological ranking value.
How can I rank in MySQL?
- These functions are always used with OVER() clause.
- The ranking functions always assign rank on basis of ORDER BY clause.
- The rank is assigned to rows in a sequential manner.
- The assignment of rank to rows always start with 1 for every new partition.
How do you rank a column in SQL?
The RANK() function creates a ranking of the rows based on a provided column. It starts with assigning “1” to the first row in the order and then gives higher numbers to rows lower in the order. If rows have the same value, they’re ranked the same.
What are the ranking functions available in SQL Server?
- ROW_NUMBER: Assigns a sequential number to each row in the result set.
- RANK: Ranks each row in the result set. …
- DENSE_RANK: Ranks each row in the result set. …
- NTILE: Divides the result set into the number of groups specified as an argument to the function.
What is trigger in SQL?
A SQL trigger is a database object which fires when an event occurs in a database. We can execute a SQL query that will “do something” in a database when a change occurs on a database table such as a record is inserted or updated or deleted. For example, a trigger can be set on a record insert in a database table.
What is SQL partitioning?
Partitioning is the database process where very large tables are divided into multiple smaller parts. … The main of goal of partitioning is to aid in maintenance of large tables and to reduce the overall response time to read and load data for particular SQL operations.
What is lead and lag in SQL?
For starters, the LEAD and LAG functions were first introduced in SQL Server 2012. They are window functions. The LEAD function is used to access data from SUBSEQUENT rows along with data from the current row. The LAG function is used to access data from PREVIOUS rows along with data from the current row.
What is the difference between RANK and Dense_rank in SQL Mcq?
Explanation: DENSE_RANK() is same as RANK() function. Only difference is returns rank without gaps. 10. Which of the following function is used when you want all tied rows to have the same ranking?
What is ROW_NUMBER in MySQL?
MySQL ROW_NUMBER() Function. The ROW_NUMBER() function in MySQL is used to returns the sequential number for each row within its partition. It is a kind of window function. The row number starts from 1 to the number of rows present in the partition.
What is difference between Rownum and ROW_NUMBER?
ROWNUM is the sequential number, allocated to each returned row during query execution. ROW_NUMBER assigns a number to each row according to its ordering within a group of rows. ROW_NUMBER is a function that returns numeric value. … ROWIDs are unique identifiers for the any row in the table.
What is SQL windowing?
In SQL, a window function or analytic function is a function which uses values from one or multiple rows to return a value for each row. (This contrasts with an aggregate function, which returns a single value for multiple rows.) … For this query, the average salary reported would be the average taken over all rows.
Why partition by is used in SQL?
A PARTITION BY clause is used to partition rows of table into groups. It is useful when we have to perform a calculation on individual rows of a group using other rows of that group. It is always used inside OVER() clause. The partition formed by partition clause are also known as Window.
What is CTE in SQL Server with example?
A Common Table Expression, also called as CTE in short form, is a temporary named result set that you can reference within a SELECT, INSERT, UPDATE, or DELETE statement. The CTE can also be used in a View.
Can we use over in MySQL?
MySQL does not currently support window functions, so over() will only yield syntax errors (or garbage, if it’s accepted regardless).